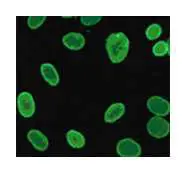
圖片

107年:(醫檢)免疫病毒(2)
抗核抗體檢測報告是核仁型( nucleolar ),結果應是下列何種圖示型態?
A圖 

B圖 

C圖 

D圖
詳細解析
本題觀念:
本題考查抗核抗體(antinuclear antibody, ANA)間接免疫螢光法(indirect immunofluorescence, IIF)在 HEp-2 細胞基質上所呈現的**核仁型(nucleolar pattern)**螢光型態辨識。核仁型 ANA 的特徵是在細胞核內出現少數(通常 1–4 個)離散、明亮的螢光點,對應核仁(nucleolus)位置,其餘核質背景螢光較弱或不顯著,與全核均勻螢光的均質型(homogeneous)或核膜強化的周邊型(peripheral)有明顯區別。
影像分析:
四個選項均為 HEp-2 細胞間接免疫螢光染色顯微鏡影像,細胞以橙紅色背景(細胞質/反染)為主,核內螢光以黃綠色呈現。
(A)(正確答案):影像中可見 7–8 個細胞,每個細胞核內有 3–5 個離散、強烈的亮黃綠色螢光點,位置固定於核仁區域;核的其餘部分螢光明顯較弱或幾乎不染色。這是典型的核仁型(nucleolar pattern):少數但強烈的焦點狀螢光點,與周圍核質形成鮮明對比。
(B):影像中細胞核內呈現密集顆粒狀/點狀螢光,顆粒均勻分佈於整個核內,整體核的明亮度高,無法辨識離散的大型亮點。此為**細點型(fine speckled)或粗點型(coarse speckled)斑點型 ANA(spe
...(解析預覽)...

升級 VIP 解鎖圖文解析